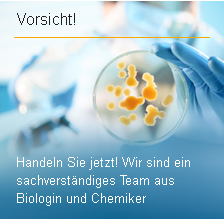
Handeln Sie jetzt

Baufeuchteuntersuchung in Berlin und Brandenburg
Bei der Baufeuchteuntersuchung wird die Raumtemperatur und Luftfeuchtigkeit sowie der Feuchtigkeitsgehalt der Bausubstanz bzw. von Baumaterialien gemessen.
Dies ist essentiell, denn eine zu hohe Luft- oder Baustofffeuchtigkeit kann zu Schäden an Gebäuden bzw. Bauteilen führen. Dabei handelt es sich um Schäden in Form von Salzausblühungen, Schimmel-, Fäule- oder Pilzbefall.
Wir sind in der Lage, Messungen ohne Beschädigung der Bauteile vorzunehmen. Es können auch Proben der Bausubstanz entnommen und später von uns analysiert werden.
Wir analysieren den Ist-Zustand und und erstellen aussagekräftige und fachgerechte Gutachten hinsichtlich der weiteren Vorgehensweise